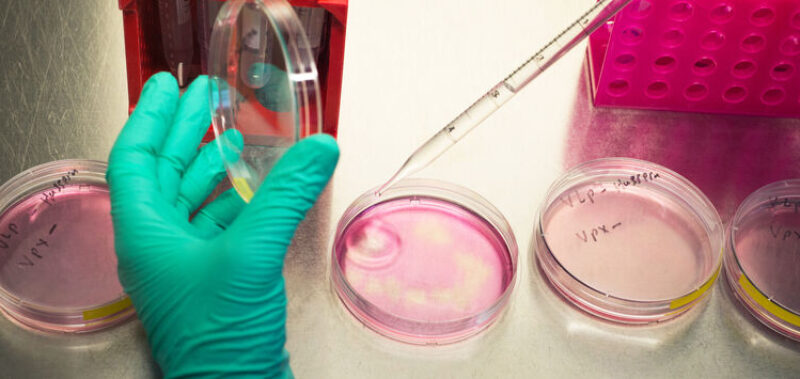

HIV-Therapie mit Cabotegravir: Depotspritzen statt täglicher Tabletten

Die EU-Kommission hat im Dezember 2020 die neuen HIV-Medikamente Vocabria® (Wirkstoff ist hier der Integrase-Hemmer Cabotegravir) und Rekambys®, eine langwirksame Version des altbewährten nicht-nukleosidischen Reverse-Transkriptase-Inhibitors (kurz NNRTI) Rilpivirin als Spritzen für die intramuskuläre Injektion zugelassen.
Die Markteinführung in Deutschland erfolgte im Mai 2021. Seither steht erstmals eine HIV-Therapie zur Verfügung, bei der keine Tabletten mehr eingenommen werden müssen: Die beiden Wirkstoffe werden alle vier oder acht Wochen in die beiden Gesäßmuskeln gespritzt – eines rechts und eines links. Das ist – nach dem Single-Tablet-Regime, also einer kompletten HIV-Therapie in einer Pille – ein nächster Meilenstein in der HIV-Behandlung.
Die Injektionstherapie ist allerdings nicht als Erst-, sondern als Erhaltungstherapie zugelassen. Sie kann also erst dann eingesetzt werden, wenn durch eine vorherige HIV-Kombinationstherapie die Menge der HIV-Kopien im Blut (Viruslast) stabil unter die Nachweisgrenze gesenkt wurde (und nur dann, wenn keine Resistenzen gegen die Wirkstoffklassen vorliegen).
Die entscheidenden Vorteile der Depotspritze liegen auf der Hand: die tägliche Tabletteneinnahme entfällt, dafür müssen die Patient*innen regelmäßig ihre HIV-Ärzt*innen aufsuchen, um die Medikamente injizieren zu lassen. Wie groß der Vorteil ist, muss jede*r für sich entscheiden. Die Tablettentherapie wird mittlerweile eigentlich von allen gut vertragen, das bedeutet: medizinisch gibt es keine Notwendigkeit zu einem Wechsel.
Dr. Markus Bickel vom Infektiologikum Frankfurt/Main allerdings, der Patient*innen im Rahmen einer Cabotegravir-Studie betreute, war überrascht, wie sehr diese veränderte Verabreichungsform die Zufriedenheit von HIV-Patient*innen verbessern konnte. „Die Studie wurde über einen ungewöhnlich langen Zeitraum hinweg durchgeführt, weshalb wir auf einen ungeheuren Datenschatz zurückgreifen können. Es war bestechend, wie zufrieden die doch recht vielen Patient*innen waren, die ich im Rahmen der Cabotegravir-Studie betreut habe“, erklärt er.
„Es war bestechend, wie zufrieden die Patient*innen der Cabotegravir-Studie waren“
Im ersten Monat wurde das Medikament in Tablettenform eingenommen, erst dann wurde auf Spritzen umgestellt. Die Rilpivirin-Tabletten sind schon seit mehreren Jahren auf dem Markt. Die Cabotegravir-Tabletten sind neu, sie wurden inzwischen in Verbindung mit der Spritzentherapie zugelassen.
Die Zufriedenheit mit der injizierbaren Therapie zeige sich nicht nur deutlich in den erhobenen Daten, berichtete Bickel gegenüber der Deutschen Aidshilfe. „Auch im persönlichen Gespräch haben mir das die Studienteilnehmenden immer wieder bestätigt.“
Dies betreffe insbesondere solche Patient*innen, die Schwierigkeiten mit der regelmäßigen Medikamenteneinnahme hatten – zum Beispiel, weil sie beruflich viel reisen und deshalb Zeitzonen und Zeitverschiebungen einrechnen müssen.
Für andere hat die Depotspritze den Vorteil, keine HIV-Medikamente mehr in der Wohnung aufbewahren zu müssen. Wichtig ist das zum Beispiel für Menschen, die ihre Infektion nicht gegenüber Familienangehörigen oder Mitbewohner*innen offenlegen können oder wollen.
In seinem Behandlungsalltag erlebt Bickel dies immer wieder etwa bei jungen schwulen Männern, die mit den Eltern und mehreren Geschwistern in beengten Verhältnissen leben, sodass ihre Privatsphäre nicht gewahrt sei.
Darüber hinaus könnte für einige HIV-Patient*innen ein weiterer Effekt von besonderer Bedeutung sein: nämlich nicht mehr jeden Morgen durch die Tabletteneinnahme an die HIV-Infektion erinnert zu werden.
Für Bickel, seit 2020 im Vorstand der Deutschen Arbeitsgemeinschaft niedergelassener Ärzte in der Versorgung HIV-Infizierter e. V. (dagnä), ist dies ein zentraler Punkt, der bei einer möglichen Therapieumstellung mit den Patient*innen intensiv diskutiert werden müsse. „Aus meiner Erfahrung sind ein großer Teil jener Patienten, die nach dieser Therapie fragen und sie unbedingt haben wollen, sogenannte Verdränger, die ihre Erkrankung nie wirklich verarbeitet haben.“
Die Vorstellung, mit Cabotegravir nun eine optimale Therapie für Menschen mit Schwierigkeiten bei der regelmäßigen Medikamenteneinnahme zu haben, sei ein Irrglauben, sagt Bickel. Gerade diese Patient*innen würde er nicht auf die Cabotegravir- Therapie einstellen, weil sie möglichweiser auch Schwierigkeiten hätten, verlässlich zur Injektion zu kommen.
Die zeitlichen Abstände der Injektionen müssen nämlich streng eingehalten werden und dürfen nur maximal eine Woche kürzer oder länger ausfallen. Nur so ist gewährleistet, dass der Medikamentenspiegel im Körper durchweg ausreichend hoch ist.
Cabotegravir-Depotspritzen: Das Behandlungsschema
Wer von Tabletten auf die Depotspritzenvariante umstellt, wird – insbesondere im ersten Jahr – die Praxis deutlich häufiger aufsuchen müssen. Zunächst werden die beiden Medikamente einen Monat lang als Tablette eingenommen, um bei möglichen Allergien oder Unverträglichkeiten sofort wieder wechseln zu können.
Danach werden die Medikamente zweimal im Vier-Wochen-Rhythmus gespritzt. Im Monat 4 der Umstellung kann entschieden werden, ob die nächsten Dosen nun weiter alle vier oder alle acht Wochen verabreicht werden.
Das Injektionsvolumen ist bei einer Vergabe im Abstand von zwei Monaten entsprechend größer: bei zweimonatiger Injektion sind es drei Milliliter. Das ist 10 Mal so viel wie eine Impfung gegen Covid-19 mit dem Biontech/Pfizer-Impfstoff – und auch die Erklärung dafür, warum man die HIV-Spritze in den großen Gesäßmuskel geben muss und nicht den kleineren Muskel der Schulter nehmen kann: Mehr Volumen bedeutet in der Regel auch größere lokale Reaktionen nach der Injektion.
Wer bei einer gut eingestellten HIV-Therapie also bislang alle drei Monate die HIV-Praxis aufsuchte, um Blutwerte überprüfen und sich ein neues Rezept ausstellen zu lassen, muss im ersten Jahr der Depotspritzentherapie mindestens achtmal, in den Folgejahren dann mindestens sechsmal vorstellig werden.
Was es auch zu bedenken gilt: Urlaube und insbesondere längere Reisen müssen langfristig mit dem Behandlungsplan koordiniert werden. Zur Überbrückung bis zum nächsten Spritzentermin können die beiden Präparate für maximal zwei Monate in Tablettenform eingenommen werden. Nicht nur für die Patient*innen, sondern auch für die Ärzt*innen stellt die Depotspritzentherapie eine terminliche wie logistische Herausforderung dar.
„Der zeitliche Aufwand für die Umstellung der Therapie ist nicht zu unterschätzen“
„Der zeitliche Aufwand für die Umstellung der Therapie ist nicht zu unterschätzen“, sagt Markus Bickel. Die Terminplanung, etwa wenn rund um Feiertage die Praxis länger geschlossen bleibt, müsse sehr vorausschauend erfolgen – und auch die Einbettung der Spritzenvergabe in den Praxisalltag müsse gut geplant werden: Das Medikament werde zunächst von den Patient*innen in der Apotheke abgeholt und dann in der Praxis für die Injektion vorbereitet. Dazu müsse ein einzelner Raum mit Sichtschutz zur Verfügung stehen; ein Blutentnahmeraum mit mehreren Behandlungsstühlen, wie es ihn in vielen Praxen gibt, sei dafür nicht geeignet.
In einer Studie wird derzeit untersucht, wie die Abläufe am besten in den Praxisalltag integriert werden können, damit es auch für Patient*innen nicht zu langen Wartezeiten kommt. Gerade unter den erschwerten Bedingungen durch Corona müsse die Umstellung besonders gut geplant werden, betont Bickel, sollen doch die Kontakte zu den Patient*innen weitestmöglich reduziert werden.
„Wir müssen dann auch darauf achten, dass wir das ärztliche und nichtärztliche Personal gut an die Technik der intramuskulären Injektion heranführen, denn sie ist nicht zu vergleichen etwa mit einer Penicillinspritze.“ Das Applikationsvolumen sei deutlich größer und die Injektion müsse langsamer durchgeführt werden, als man dies von einer Depotspritze im Praxisalltag sonst kenne.
Unklar sei noch, ob und wie der größere Aufwand in den Praxen auch besser vergütet wird.
Cabotegravir-Depotspritzen als PrEP
Cabotegravir eignet sich aber nicht nur für die HIV-Behandlung, sondern wird derzeit auch als HIV-Prophylaxe-Medikament erprobt. Die ersten Zwischenergebnisse sind vielversprechend. Doch ob und wo sich Cabotegravir für die PrEP durchsetzen wird, ist noch offen – aus mehreren Gründen.
Zum einen wird wie bei der HIV-Therapie auch eine PrEP mit Cabotegravir nur schrittweise – also erst nach der Tabletteneinnahme – zur Zwei-Monatsspritze führen können. „Und auch hier ist eine gute Adhärenz (Einnahmetreue, Anm. d. Red.) Voraussetzung, um den Medikamentenspiegel gleichbleibend hoch zu halten und damit den Schutz gewährleisten und Resistenzen vermeiden zu können“, betont Armin Schafberger, Medizinreferent der Deutschen Aidshilfe.
Anders als bei der bisherigen PrEP mit den Wirkstoffen Tenofovir und Emtricitabin kann die PrEP mit Cabotegravir-Depotspritzen zudem nicht kurzfristig beendet werden. Der Grund: Der Integrasehemmer bleibt nach Beendigung der Spritzenvergabe noch bis zu einem Jahr im Blut nachweisbar. Kommt es dann zu einer HIV-Infektion, reicht die geringe Dosis nicht aus, um das Virus zu unterdrücken, sodass sich leicht Mutanten durchsetzen. Eine ideale Situation also für die Bildung von Resistenzen und eine denkbar schlechte für eine spätere Behandlung der HIV-Infektion.
Um dies zu vermeiden, wird nach der Beendigung der Cabotegravir-PrEP voraussichtlich ein Jahr lang eine orale PrEP mit Tenofovir und Emtricitabin genommen werden müssen, um sich vor einer HIV-Infektion möglichst sicher zu schützen. Genaueres wird man aber erst nach der Zulassung von Cabotegravir zur PrEP wissen.
Eine PrEP mit Cabotegravir muss also gut überlegt und für mehrere Jahre angedacht sein. Nur dann lohnt sich die lange Einleitungs- bzw. der Ausstiegsphase.
Cabotegravir-PrEP für (cis) Frauen
So nachteilig die Handhabung der Cabotegravir-PrEP gegenüber der bewährten oralen PrEP ist: für viele (cis) Frauen könnte sie enorme Vorteile bieten.
Die Datenlage für die Wirksamkeit der bislang in Europa eingesetzten PrEP-Medikamente bei Frauen ist schlecht. Rekrutiert wurde gezielt vor allem unter Männern, die Sex mit Männern haben. Die in afrikanischen Ländern durchgeführten PrEP-Studien hingegen zeigten bei Frauen gemischte oder sogar enttäuschende Ergebnisse.
Weil sich die Wirkstoffe der bisherigen PrEP-Medikamente nicht so gut in der Vaginalschleimhaut anreichern und auch schneller wieder abgebaut werden, sollten Frauen besser keine Tabletteneinnahme auslassen, um nicht die Schutzfunktion zu verlieren; bei Männern kann auch mal eine Dosis entfallen, ohne dass der Schutz verlorengeht.
Hinzu kommt, dass das bisherige Medikament zur HIV-PrEP auch als HIV-Medikament bekannt ist, sodass PrEP-Userinnen Gefahr laufen, als HIV-positiv zu gelten und Diskriminierungen ausgesetzt zu sein. Aufgrund dieses sozialen Drucks wird oft versucht, die Tabletteneinnahme zu verbergen, was die Therapietreue erschwert.
„Die Cabotegravir-PrEP könnte für Frauen in afrikanischen Ländern ein Game-Changer werden“
Die Zwei-Monats-Spritze mit Cabotegravir verhindert HIV-Infektionen bei Frauen deutlich wirksamer als die täglich eingenommene PrEP mit Tenofovir und Emtricitabin.
„Die Cabotegravir-PrEP könnte für Frauen in afrikanischen Ländern tatsächlich ein Game-Changer werden“, sagt DAH-Medizinreferent Armin Schafberger. Eine Spritze, die in einer Klink oder Praxis gegeben werde, ändere die Situation, zumal in vielen afrikanischen Ländern auch die Schwangerschaftsverhütung bereits mit Depotspritzen vorgenommen werde. Diese Frauen könnten sich dann mit einer weiteren Injektion zugleich gegen eine HIV-Infektion schützen.
Diesen Beitrag teilen